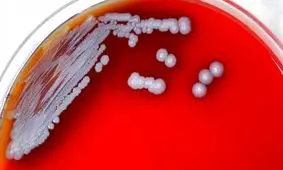
باکتری یک بیماری نادر و خطرناک از آب و خاک جنوب آمریکا سر درآورد

بیماری خطرناک
-

بیماری های خطرناکی که با «حسادت» به سراغتان میآید!
بسیاری از افراد دارای حس قوی حسادت بوده و توان دیدن موفقیتهای دیگران را ندارند. باید به این افراد یادآوری کرد که…
-
باکتری یک بیماری نادر و خطرناک از آب و خاک جنوب آمریکا سر درآورد
مقامات بهداشتی آمریکا روز چهارشنبه اعلام کردند که نمونهبرداریهای انجام شده از آب و خاک ایالات میسیسیپی در جنوب این…
-

کرونا در پاییز نگران کنندهتر از اسفند خواهد بود
رئیس مجتمع بیمارستانی امام خمینی(ره)، وضعیت کرونا در پاییز را نگران کننده تر از اسفند ۹۸ پیش بینی کرد.
-

کرونا برای دیابتیها خطرناکتر است
فوق تخصص غدد داخلی و متابولیسم در تهران گفت: بد حال شدن، بستری شدن در بیمارستان، بستری شدن در آی سی یو و حتی مرگ به…
-

کرونا در چه صورت دوباره خطرناک می شود
رئیس کل سازمان نظام پزشکی ایران، معتقد است که تا قبل از فرا رسیدن فصل پاییز و شیوع آنفلوانزا، باید تکلیف بیماری کووید…
-

-

اگر این نشانهها را دارید در معرض ابتلا به یک بیماری خطرناک هستید
یکی از بیماریهایی که با درد شدید در بدن ظاهر میشود و میتواند سبب التهاب شود، سندرمی به نام درد منطقهای پیچیده CRPS …
-

ارتباط تاری چشم و این بیماری خطرناک!
چشم نباید تار ببیند، داشتن دید مبهم تا حد زیادی میتواند ناخوشایند باشد و باعث ایجاد ترس در افراد شود.
-

بیماری خطرناکی که با مصرف آدامس سراغتان میآید
مطالعات نشان میدهد مصرف مواد خوراکی حاوی افزودنی E ۱۷۱ بر میکروبهای روده و همچنین التهاب روده تاثیر میگذارد.
-

بیماری خطرناکی که گیاهخواران را هدف می گیرد
یکی از بیماری هایی که طرفداران رژیم گیاهخواری را مورد هدف قرار می دهد کم خونی است.
